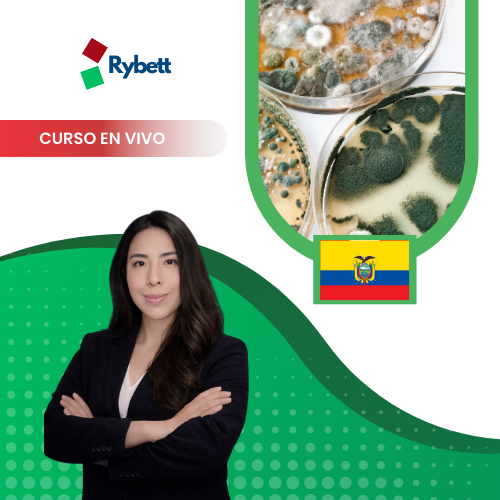
Ecología Molecular Microbiana

Ecología Molecular Microbiana
¿Qué aprenderás en este curso?
En este curso, aprenderás los fundamentos de la ecología molecular microbiana y el papel de los microorganismos en los ecosistemas, explorando su diversidad funcional en ambientes naturales, el ciclo de nutrientes (carbono, nitrógeno y fósforo) y sus interacciones con plantas, suelos y ambientes extremos. Profundizarás en cómo los microorganismos influyen en la dinámica de los ecosistemas y en las relaciones microbio-microbio y microbio-planta. Además, adquirirás competencias en técnicas moleculares aplicadas al estudio de comunidades microbianas, desde el aislamiento de ADN y la extracción de material genético hasta la amplificación de genes marcadores como ITS y 16S rRNA. Finalmente, practicarás el uso de QIIME 2 para el análisis de secuencias y la interpretación de comunidades microbianas, aplicando herramientas bioinformáticas en investigación ambiental, agrícola y biotecnológica.
Metodología
- El curso se ofrece en modalidad sincrónica, lo que te permitirá participar en sesiones en vivo a través de Zoom, con la opción de visualizar las grabaciones posteriormente. Los materiales del curso estarán disponibles para descarga.
Proceso de inscripción
- Puedes inscribirte en el curso en línea a través de nuestra página web.
- También tienes la opción de adquirir el curso mediante un asesor, contactándonos por WhatsApp haciendo clic aquí.
Estado del curso
- Disponibilidad: Vacantes abiertas.
- Temario y fechas: Consulta el brochure en la parte inferior de esta página o contacta a nuestro asesor haciendo click aquí.
- Fecha de inicio: 20 de febrero del 2026
- Fecha de finalización: 21 de febrero del 2026
- Número de módulos: 2
- Duración total: 4 horas.
- Certificación total: 12 horas.
Requisitos
- Una PC o laptop.
- Motivación para aprender y mejorar tus habilidades.
Certificación
- Al finalizar el curso, recibirás un certificado gratuito emitido por el Centro de formación en ciencias, ingeniería e idiomas S.A.C.
- También tienes la opción de obtener un certificado adicional emitido por una Universidad con la que mantenemos convenio.
Te invitamos a unirte a nuestro grupo de WhatsApp dando click aquí
Contenido del Curso
Información
$13.00 El precio original era: $13.00.$10.00El precio actual es: $10.00.